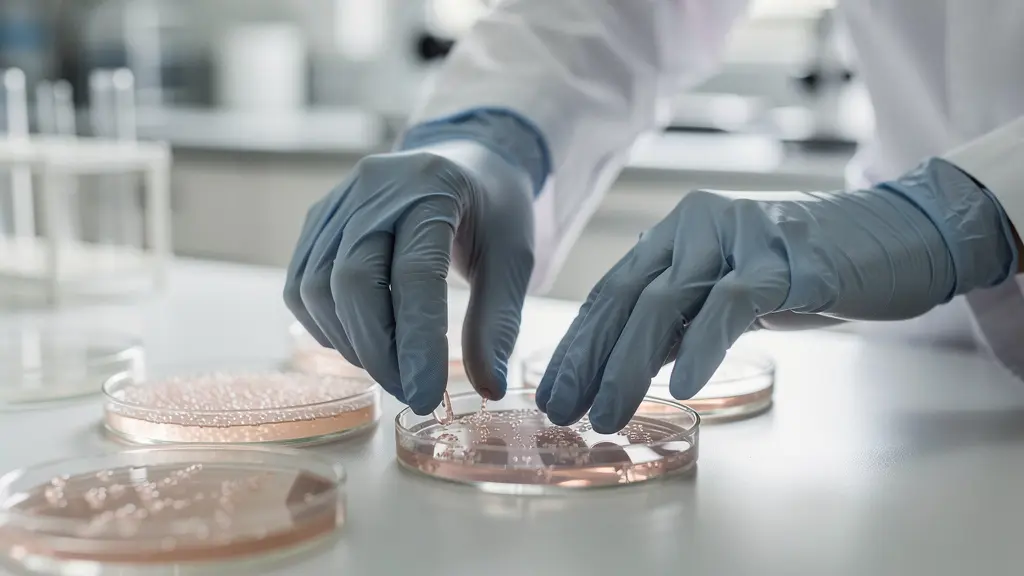
Vue microscopique de cellules de branchies en culture avec structures cellulaires visibles

Contrairement à l’idée reçue, le danger des nanomatériaux ne vient pas de leur toxicité chimique directe, que l’on sait mesurer. Il émerge de leurs propriétés physiques uniques qui transforment les protocoles d’évaluation standards en pièges, masquant les vrais risques : les effets « cheval de Troie », l’asphyxie cellulaire et les impacts en cascade sur des générations entières. Cet article démontre pourquoi nous devons changer non pas nos outils, mais notre façon de penser la toxicité pour protéger efficacement la biodiversité.
Face à un polluant, notre premier réflexe, en tant que scientifiques, est de le quantifier et de mesurer sa toxicité. C’est une approche héritée de la chimie classique : une dose, une réponse. Pourtant, lorsque nous appliquons cette logique aux nanomatériaux, nous faisons face à une vague de résultats contradictoires et de catastrophes écologiques inexpliquées. Le problème n’est pas que ces particules sont intrinsèquement « méchantes », mais qu’elles ne jouent pas selon les règles de la toxicologie traditionnelle. Leur danger réside moins dans leur composition chimique que dans leur taille, leur forme et leur surface, des propriétés physiques qui leur permettent d’interagir avec le vivant de manière totalement inédite.
L’approche standard consiste à exposer un organisme à une substance et à observer les effets directs, comme la mortalité. C’est le fondement de la toxicologie réglementaire. Or, cette méthode est souvent aveugle aux mécanismes d’action des nanomatériaux. Elle ne voit pas comment une nanoparticule peut devenir un « cheval de Troie » pour un pesticide, comment elle peut affamer une cellule sans la empoisonner chimiquement, ou comment son impact peut se répercuter, invisible, sur plusieurs générations. Nous sommes face à une pollution d’un nouveau genre, qui exige non pas de meilleurs instruments de mesure, mais une révolution de nos protocoles de pensée.
Cet article va au-delà du constat d’échec. En explorant des cas concrets, des daphnies aux abeilles en passant par la chaîne alimentaire marine, nous allons décortiquer les erreurs méthodologiques qui nous empêchent de voir la véritable menace. L’objectif est de comprendre pourquoi les règles de la physique à l’échelle nanométrique dictent une nouvelle forme de toxicité, et comment nous, biologistes, chercheurs et responsables, devons adapter nos stratégies pour protéger la biodiversité de ce péril invisible.
Pour naviguer à travers cette analyse complexe, cet article est structuré pour répondre à des questions précises et contre-intuitives, révélant pas à pas les failles de nos approches actuelles. Le sommaire ci-dessous vous guidera à travers les mécanismes cachés de la nanotoxicologie.
Sommaire : Décrypter la toxicité cachée des nanomatériaux
- Pourquoi les daphnies meurent-elles en présence de dioxyde de titane nano ?
- Comment un mélange de nanos et de pesticides devient-il 10 fois plus mortel pour les abeilles ?
- Mort immédiate ou baisse de fertilité sur 3 générations : quel impact surveiller chez les poissons ?
- L’erreur de protocole qui fait croire qu’une nanoparticule est toxique alors qu’elle a juste affamé les cellules
- Problème éthique : comment utiliser des cellules de branchies in vitro pour prédire la toxicité sur une truite ?
- Pourquoi les boues d’épuration épandues dans les champs sont-elles une bombe à retardement nano ?
- Pourquoi les nanos mangées par les algues se retrouvent-elles concentrées dans le thon ?
- Pourquoi la nanotoxicologie réglementaire est-elle le plus gros frein à l’innovation nano actuelle ?
Pourquoi les daphnies meurent-elles en présence de dioxyde de titane nano ?
Les daphnies, ou puces d’eau, sont des organismes sentinelles en écotoxicologie. Leur sensibilité aux polluants en fait un excellent indicateur de la qualité de l’eau. Or, face au dioxyde de titane (TiO2) sous forme nanoparticulaire, un composant courant des crèmes solaires et des peintures, leur réaction déroute les protocoles standards. À l’obscurité, le TiO2 nano est relativement inerte. Cependant, le tableau change radicalement sous l’effet de la lumière. La toxicité n’est donc pas une propriété intrinsèque de la substance, mais une toxicité contextuelle, déclenchée par un facteur externe : les rayons UV.
Sous l’effet des UV, les nanoparticules de TiO2 deviennent photoactives et génèrent des espèces réactives de l’oxygène (ERO), provoquant un stress oxydatif intense qui endommage les cellules des daphnies. Une étude révèle que la toxicité du TiO2 se manifeste à des concentrations de quelques mg/litre sous radiation solaire, des niveaux plausibles dans des environnements aquatiques exposés. Ce phénomène illustre une première faille majeure des tests classiques : un protocole réalisé en laboratoire, à l’abri des UV, pourrait conclure à l’innocuité d’une substance qui s’avère mortelle dans des conditions réelles.
Plus subtilement, les nanoparticules peuvent aussi avoir un effet purement physique. Elles peuvent s’agréger et adhérer à l’exosquelette des daphnies, entravant leur mobilité et leur capacité à se nourrir. L’organisme ne meurt pas empoisonné au sens chimique, mais d’épuisement ou de faim. C’est une distinction cruciale que les tests toxicologiques classiques, focalisés sur la dose létale (DL50), peinent à capturer. Nous ne cherchons pas une substance toxique, mais une particule physiquement perturbatrice.
Comment un mélange de nanos et de pesticides devient-il 10 fois plus mortel pour les abeilles ?
Le drame des abeilles est souvent attribué aux seuls pesticides. Cependant, la réalité est plus complexe et met en lumière un des mécanismes les plus pervers de la nanotoxicologie : l’effet « cheval de Troie ». Seules, certaines nanoparticules peuvent être peu toxiques. Seul, un pesticide à faible dose peut être en dessous du seuil de danger. Mais ensemble, ils forment un cocktail redoutable. La nanoparticule, de par sa très grande surface réactive, peut adsorber les molécules de pesticides présentes dans l’environnement. Elle devient alors un vecteur ultra-efficace, capable de transporter ces poisons directement à travers les cuticules et les barrières biologiques de l’abeille, qui seraient autrement restées imperméables.

Ce phénomène d’effet synergique est dramatiquement sous-évalué. Les tests réglementaires évaluent les substances une par une, dans des conditions de laboratoire stériles. Ils ignorent la « soupe chimique » présente dans un champ traité, où les fongicides, herbicides et adjuvants interagissent. Des études ont montré que certains pesticides agissent en synergie avec des agents pathogènes, affaiblissant le système immunitaire de l’abeille et la rendant plus vulnérable aux maladies. L’ajout de nanoparticules à cette équation ne fait qu’amplifier le problème en augmentant la biodisponibilité des toxines.
On observe ainsi une mortalité aiguë chez les abeilles exposées à des mélanges, même si chaque composant pris isolément est à une dose considérée comme « sûre ». Le protocole standard, en testant les substances en silo, est structurellement incapable de prédire ce type de danger. Il ne mesure pas la toxicité d’un produit, mais celle, artificielle, d’un ingrédient isolé de son contexte. Pour l’abeille, la menace n’est pas une seule balle, mais une nuée de projectiles dont les nanomatériaux sont les accélérateurs.
Mort immédiate ou baisse de fertilité sur 3 générations : quel impact surveiller chez les poissons ?
En écotoxicologie aquatique, le critère dominant reste la mortalité aiguë. C’est un indicateur simple, binaire et rapide à mesurer. On expose un lot de poissons à un polluant et on compte les morts après 96 heures. Ce protocole, bien qu’utile, est d’une myopie alarmante face aux nanomatériaux. Il est conçu pour détecter des poisons violents, pas des saboteurs silencieux. Or, les impacts les plus dévastateurs des nanoparticules sont souvent sublétaux et transgénérationnels. Un poisson peut survivre à une exposition, paraître en bonne santé, mais subir des dommages à son ADN ou à son système reproducteur qui ne se manifesteront que chez ses descendants.
Des études sur différentes espèces ont mis en évidence des baisses de fertilité, des malformations chez les larves ou une sensibilité accrue aux maladies sur plusieurs générations après une exposition unique des parents. Ces effets à long terme, qui menacent la survie même d’une population, sont complètement invisibles pour un test de toxicité aiguë. Les protocoles réglementaires actuels ignorent en grande partie ces effets sublétaux et indirects, car ils sont plus longs, plus coûteux et plus complexes à évaluer.
Le choix de l’indicateur détermine ce que l’on trouve. En se focalisant sur la « mort immédiate », nous déclarons à tort comme « sûres » des substances qui érodent lentement la résilience des écosystèmes. La question que nous devons nous poser n’est plus « combien de poissons sont morts ? », mais « la population est-elle encore capable de se reproduire sainement dans trois générations ? ». Cela implique un changement de paradigme : passer d’une toxicologie de l’individu à une écotoxicologie des populations, qui intègre le temps long et la dynamique des écosystèmes.
L’erreur de protocole qui fait croire qu’une nanoparticule est toxique alors qu’elle a juste affamé les cellules
L’un des biais les plus contre-intuitifs dans les tests de cytotoxicité in vitro est l’interférence des nanoparticules avec les réactifs du test eux-mêmes. De nombreux tests standards mesurent la viabilité cellulaire en utilisant des colorants ou des substrats qui réagissent avec des enzymes de cellules vivantes pour produire un signal lumineux ou coloré. Moins il y a de signal, plus on en déduit que les cellules sont mortes. C’est ici que le piège se referme. Les nanoparticules, notamment métalliques ou carbonées, possèdent une surface active énorme qui peut adsorber les colorants ou inhiber les enzymes du test sans avoir le moindre effet sur les cellules elles-mêmes.
Dans un tel scénario, le signal lumineux diminue non pas parce que les cellules sont mortes, mais parce que les nanoparticules ont « mangé » le réactif ou bloqué la réaction. Le résultat du test est un faux positif : il crie à la toxicité là où il n’y a qu’une simple interférence physique ou chimique. Pire encore, les nanos peuvent aussi enrober les cellules, formant une couche qui les isole de leur milieu de culture. Les cellules meurent alors non pas d’empoisonnement, mais d’asphyxie ou de faim cellulaire, privées de nutriments. Le test détecte une mort cellulaire et la classe comme « toxicité », alors que le mécanisme est purement mécanique.
La toxicité des nanomatériaux dépend de multiples paramètres physico-chimiques : composition chimique, taille, forme, structure… Chaque nanomatériau possède un profil toxicologique qui lui est propre.
Cette distinction est fondamentale. Elle prouve que transposer un protocole de chimie à un problème de physique est une erreur méthodologique. Cela exige une batterie de contrôles supplémentaires, systématiquement oubliés dans les tests de routine, pour s’assurer que la particule n’interfère pas avec l’essai. Sans cette précaution, nous risquons de classer comme toxiques des matériaux inoffensifs, ou pire, de mal comprendre le véritable mécanisme de toxicité d’un matériau dangereux.
Checklist d’audit pour un protocole de nanotoxicologie :
- Contrôle des interférences : Le protocole inclut-il une étape pour tester si les nanoparticules interagissent avec les réactifs (colorants, substrats) en l’absence de cellules ?
- Analyse de l’adsorption : A-t-on vérifié si les nutriments essentiels du milieu de culture sont adsorbés à la surface des nanoparticules, pouvant induire une « faim cellulaire » ?
- Caractérisation in situ : Les propriétés des nanoparticules (taille, agrégation, charge) sont-elles mesurées directement dans le milieu de culture, et non seulement sous leur forme sèche initiale ?
- Observation morphologique : Le protocole se base-t-il uniquement sur un signal biochimique, ou inclut-il une observation microscopique pour détecter des effets physiques (enrobage, agrégation sur les cellules) ?
- Validation multi-tests : La conclusion de toxicité est-elle basée sur un seul test de viabilité, ou est-elle confirmée par plusieurs essais mesurant différents paramètres (intégrité membranaire, activité métabolique, apoptose) ?
Problème éthique : comment utiliser des cellules de branchies in vitro pour prédire la toxicité sur une truite ?
Face à la nécessité éthique de réduire l’expérimentation animale, la recherche s’est tournée vers des méthodes alternatives, notamment les tests in vitro sur des cultures cellulaires. L’idée est séduisante : au lieu de tester un polluant sur une centaine de truites, on l’applique sur une culture de cellules de branchies de truite en boîte de Petri. C’est plus rapide, moins cher et éthiquement plus défendable. De nombreux kits de bioessais standardisés permettent aujourd’hui de caractériser l’écotoxicité d’un échantillon sur des lignées cellulaires spécifiques, offrant une alternative prometteuse aux tests sur organismes entiers.
Cependant, cette approche soulève un immense défi de transposition. Une culture cellulaire est un système simplifié à l’extrême. Elle ne reproduit pas la complexité d’un organisme vivant. Une truite possède un foie pour détoxifier les substances, un système immunitaire pour réagir à une agression, et des branchies dont l’architecture 3D complexe et le mucus protecteur n’ont rien à voir avec une monocouche de cellules au fond d’un puits en plastique. Une nanoparticule pourrait n’avoir aucun effet sur des cellules isolées, mais provoquer une inflammation massive ou bloquer la respiration une fois en contact avec le tissu branchial complexe d’un poisson vivant.
Le passage de l’in vitro (en laboratoire) à l’in vivo (dans le vivant) est donc loin d’être direct. Les modèles in vitro sont excellents pour le criblage à haut débit (tester rapidement des centaines de substances) et pour étudier des mécanismes d’action spécifiques au niveau cellulaire. Mais ils ne peuvent, à eux seuls, prédire de manière fiable la toxicité d’une substance à l’échelle d’un organisme entier, et encore moins à celle d’un écosystème. Nous sommes face à un compromis entre pertinence éthique et pertinence écologique. Protéger l’individu en laboratoire ne doit pas nous faire oublier la protection de la population en milieu naturel.
Pourquoi les boues d’épuration épandues dans les champs sont-elles une bombe à retardement nano ?
Le cycle de vie de nombreux produits de consommation contenant des nanomatériaux (cosmétiques, textiles, peintures) se termine dans nos eaux usées. Les stations d’épuration, bien que performantes pour traiter la pollution organique, ne sont pas conçues pour éliminer les nanoparticules. Celles-ci ont tendance à s’agréger et à se lier à la matière organique, se concentrant massivement dans les boues d’épuration résiduaires. Ces boues, riches en nutriments, sont ensuite souvent valorisées en agriculture et épandues sur les champs comme fertilisant. C’est ainsi que nous créons, sans le vouloir, une voie de contamination directe des sols et des écosystèmes terrestres.
L’ampleur du problème est considérable. Chaque année, ce sont des centaines de milliers de tonnes de nanomatériaux qui sont produites ou importées. Rien qu’en France, les déclarations font état de près de 305 000 tonnes de substances nanoparticulaires produites et importées, avec en tête la silice, le noir de carbone et le dioxyde de titane. Une fraction non négligeable de ce volume se retrouvera inévitablement dans les boues d’épuration. Une fois dans le sol, ces nanoparticules peuvent affecter les communautés microbiennes essentielles à la fertilité, être absorbées par les vers de terre et entrer dans la chaîne alimentaire terrestre, ou être entraînées par le ruissellement vers les cours d’eau.
L’épandage des boues transforme ainsi les sols agricoles en puits de stockage à long terme pour des polluants persistants. Contrairement à des polluants organiques qui peuvent se dégrader, de nombreuses nanoparticules (métalliques, oxydes) sont stables et s’accumulent année après année. Chaque épandage est un nouvel apport, créant une bombe à retardement dont nous commençons à peine à mesurer les conséquences sur la santé des sols, la qualité des cultures et la biodiversité environnante. Le sol n’est pas une poubelle, mais un milieu vivant complexe que nous chargeons de polluants dont nous ignorons le devenir à long terme.
Pourquoi les nanos mangées par les algues se retrouvent-elles concentrées dans le thon ?
Le principe de la bioamplification (ou biomagnification) est un concept clé en écotoxicologie. Il décrit comment la concentration d’un polluant persistant augmente à chaque niveau de la chaîne alimentaire. Les nanomatériaux, en particulier ceux qui sont peu dégradables, sont des candidats parfaits pour ce processus. Tout commence à la base de la chaîne alimentaire aquatique : le phytoplancton et les micro-algues. Ces organismes filtrent l’eau et peuvent absorber ou adsorber les nanoparticules présentes, même à des concentrations très faibles, quasi indétectables.
Le zooplancton (comme les daphnies) se nourrit ensuite de ces algues, ingérant non pas une, mais des milliers d’algues contaminées. La concentration de nanoparticules dans le zooplancton est déjà bien plus élevée que dans l’eau. Puis, un petit poisson mange des milliers de ces zooplanctons, concentrant encore davantage le polluant. Et ainsi de suite, jusqu’au sommet de la chaîne : le prédateur final, comme le thon ou le dauphin, en consommant de nombreux poissons eux-mêmes contaminés, accumule des concentrations de polluants qui peuvent être des millions de fois supérieures à celle de l’eau. Les études sur les PCB, un autre polluant persistant, ont montré que le phytoplancton a concentré un millier de fois les PCB par rapport à l’eau, et les prédateurs finaux atteignent des niveaux encore plus élevés.
Le thon ne nage pas dans une « soupe » de nanoparticules, mais il se nourrit de proies qui, elles-mêmes, en ont fait leur régime. C’est ainsi que des substances libérées à l’autre bout du monde peuvent se retrouver dans notre assiette. Ce mécanisme est particulièrement préoccupant pour les nanoparticules car leur petite taille facilite leur transfert à travers les membranes biologiques et leur stockage dans les tissus, notamment graisseux. Chaque maillon de la chaîne alimentaire agit comme une éponge, et le prédateur final presse toutes ces éponges. Nous ne sommes pas à l’abri ; en tant que super-prédateurs, nous sommes au bout de cette chaîne de contamination.
À retenir
- Les protocoles de toxicologie chimique classiques sont inadaptés aux nanomatériaux car ils ignorent les effets physiques (taille, surface) qui sont souvent prédominants.
- Les dangers les plus insidieux proviennent des effets indirects que les tests standards ne mesurent pas : effet « cheval de Troie », synergies avec d’autres polluants et impacts transgénérationnels.
- La bioamplification concentre les nanoparticules persistantes au sommet de la chaîne alimentaire, menaçant les prédateurs (dont l’homme) même si la pollution initiale dans l’environnement est faible.
Pourquoi la nanotoxicologie réglementaire est-elle le plus gros frein à l’innovation nano actuelle ?
Le paradoxe de la nanotoxicologie réglementaire est qu’en cherchant à protéger, elle paralyse. Le développement des nanotechnologies est exponentiel, mais notre compréhension des risques reste limitée et fragmentée. Face à cette incertitude, le principe de précaution pousse les agences réglementaires à exiger des dossiers d’évaluation de plus en plus complexes pour chaque nouveau nanomatériau. Cependant, comme nous l’avons vu, les outils pour remplir ces dossiers – les tests standards – sont souvent inadaptés. Cela crée un brouillard réglementaire où ni les industriels ni les autorités ne savent exactement quelles données sont pertinentes.
Le développement récent de ces substances implique une compréhension encore limitée de leurs risques potentiels. Une substance nanoparticulaire peut présenter un profil de danger différent, comme la capacité à traverser les barrières biologiques. Les connaissances restent incomplètes.
– Ministère de la Transition écologique, Politiques publiques Nanomatériaux
Cette situation a un effet dissuasif sur l’innovation, en particulier pour les petites et moyennes entreprises. Le coût et la durée des études de toxicologie pour un seul nanomatériau peuvent être prohibitifs. De plus, la crainte d’un classement « toxique » basé sur un protocole potentiellement biaisé ou d’un changement de réglementation à court terme freine les investissements en R&D. Les données officielles le confirment : le nombre d’entités déclarant des substances nanoparticulaires en France est en baisse. Alors qu’on pourrait s’attendre à une augmentation avec l’essor des nanotechnologies, on constate qu’environ 1100 entités françaises ont déclaré une substance en 2022, un chiffre en diminution. Cela suggère un retrait ou une consolidation du marché, où seuls les grands groupes peuvent supporter le fardeau réglementaire.
L’enjeu n’est pas d’affaiblir la réglementation, mais de la rendre plus intelligente. Nous avons besoin d’une nanotoxicologie prédictive, basée sur la compréhension des mécanismes d’action plutôt que sur une accumulation de tests standards. Il faut développer des approches par catégorie (« read-across »), où des matériaux aux propriétés physiques similaires peuvent être évalués ensemble, et investir dans des modèles in vitro plus pertinents et des lignes directrices claires et harmonisées au niveau international. Sans cette évolution, la réglementation restera un obstacle qui protège mal et innove peu.
Face à cette complexité, il est impératif d’adopter une approche critique et adaptative. La protection efficace de la biodiversité contre les menaces émergentes comme les nanomatériaux ne passera pas par l’application rigide de vieilles recettes, mais par une refonte audacieuse de nos méthodes d’évaluation des risques, en plaçant la compréhension des mécanismes physiques au cœur de notre démarche scientifique.